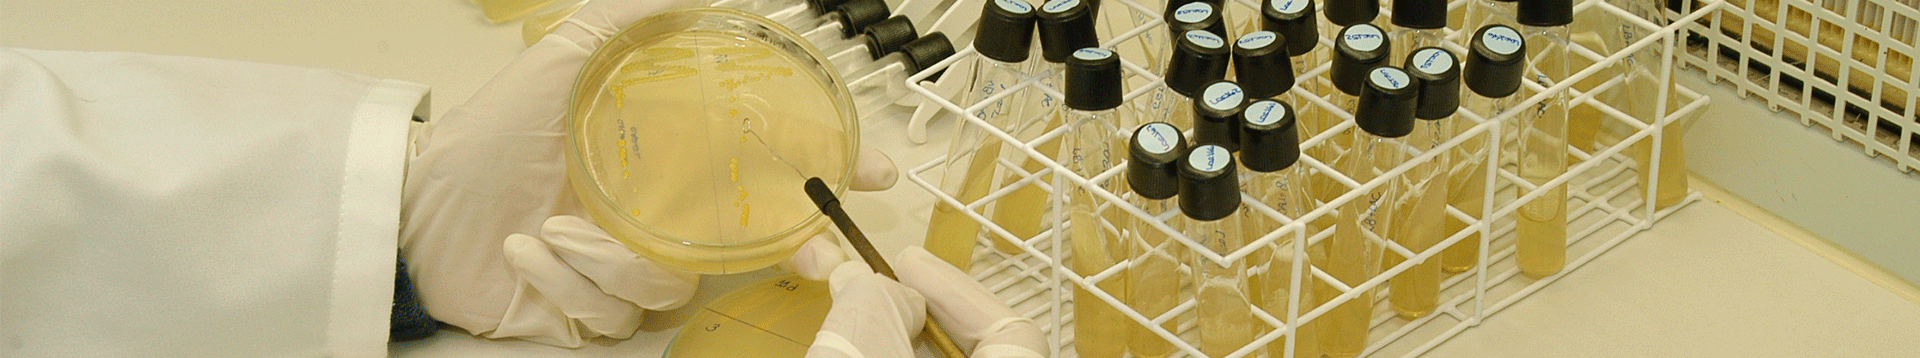

O Instituto de Biotecnologia da Universidade de Caxias do Sul iniciou suas atividades em 1979 e sua atuação ao longo de mais de quatro décadas de existência tem sido no sentido de qualificar o ensino de graduação e pós-graduação oferecido pela Universidade, de avançar na pesquisa científica e tecnológica, estendendo à sociedade os benefícios do conhecimento produzido por seu grupo de pesquisadores.
Saiba mais
Biotecnologia Industrial
Área da biotecnologia que utiliza organismos vivos ou seus produtos para desenvolver e/ou aprimorar os processos industriais. Contribui com a geração de materiais e produtos de alto valor agregado. Pode envolver as áreas: farmacêutica, alimentícia, química e energética.

Biotecnologia em Saúde
Área da biotecnologia que atua na prevenção e tratamento de doenças humanas e animais por meio do desenvolvimento de vacinas e medicamentos. Atua no desenvolvimento e uso de testes toxicológicos, de biomarcadores e diagnóstico.

Biotecnologia Ambiental
Área da biotecnologia que usa e aplica estratégias biológicas na conservação do meio ambiente. Pode atuar na bioprospecção de microrganismos e plantas, bem como de seus produtos, e na biorremediação e tratamento e uso de resíduos industriais.

Biotecnologia Agrícola
Área da biotecnologia que busca aumentar a produtividade vegetal e animal. Atua através do melhoramento de espécies, controle de pragas e doenças e desenvolvimento de bioinsumos.